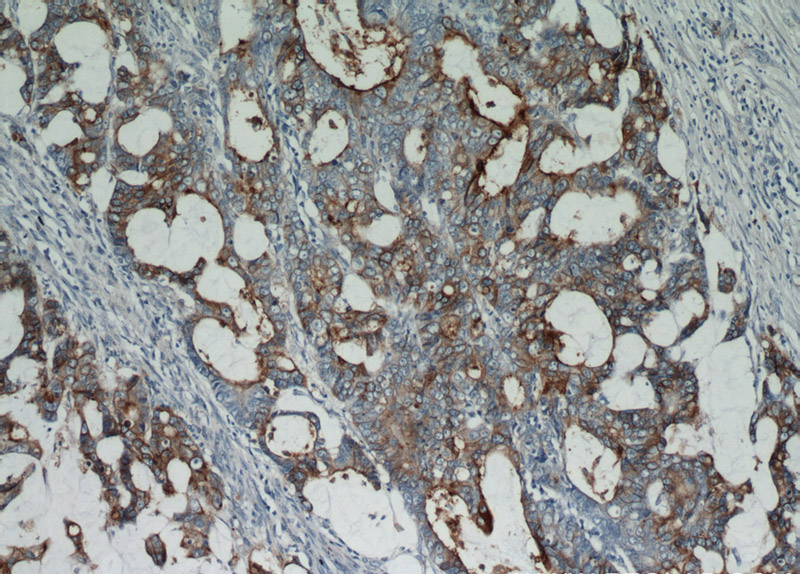
Immunohistochemical of paraffin-embedded human colon cancer using Catalog No:109242(CEA antibody) at dilution of 1:50 (under 10x lens)
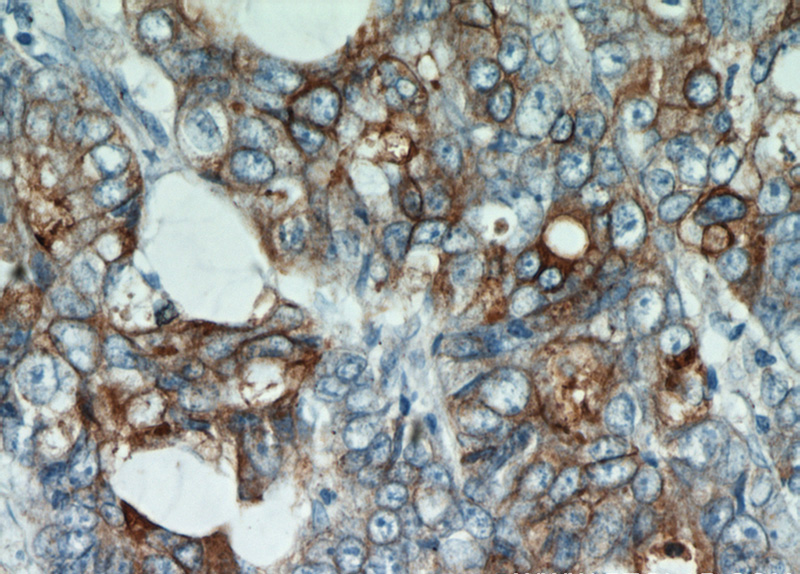
Immunohistochemical of paraffin-embedded human colon cancer using Catalog No:109242(CEA antibody) at dilution of 1:50 (under 40x lens)

-
Product Name
CEA antibody
- Documents
-
Description
CEA Rabbit Polyclonal antibody. Positive IHC detected in human colon cancer tissue, human colon tissue, human lung cancer tissue, human pancreas cancer tissue, human stomach cancer tissue.
-
Tested applications
ELISA, IHC
-
Species reactivity
Human; other species not tested.
-
Alternative names
Carcinoembryonic antigen antibody; CD66e antibody; CEA antibody; CEACAM5 antibody; DKFZp781M2392 antibody; Meconium antigen 100 antibody
-
Isotype
Rabbit IgG
-
Preparation
This antibody was obtained by immunization of CEA recombinant protein (Accession Number: NM_004363). Purification method: Antigen affinity purified.
-
Clonality
Polyclonal
-
Formulation
PBS with 0.1% sodium azide and 50% glycerol pH 7.3.
-
Storage instructions
Store at -20℃. DO NOT ALIQUOT
-
Applications
Recommended Dilution:
IHC: 1:20-1:200
-
Validations
Immunohistochemical of paraffin-embedded human colon cancer using Catalog No:109242(CEA antibody) at dilution of 1:50 (under 10x lens)
Immunohistochemical of paraffin-embedded human colon cancer using Catalog No:109242(CEA antibody) at dilution of 1:50 (under 40x lens)
-
Background
Carcinoembryonic antigen (CEA), also known as CEACAM5 or CD66e, is a cell surface glycoprotein belonging to the immunoglobulin superfamily, mainly serving as a cell adhesion molecule mediating intercellular contact by both homophilic and heterophilic binding (PMID: 21731662). CEA inhibits anoikis and plays a role in tumorigenesis and metastasis. CEA has been found to be overexpressed in a wide variety of human cancers, including colon, breast, and lung (PMID: 17167768). CEA is a tumor marker and is routinely exploited for diagnosis.
-
References
- Zhou PH, Zheng JB, Wei GB. Lentivirus-mediated RASSF1A expression suppresses aggressive phenotypes of gastric cancer cells in vitro and in vivo. Gene therapy. 22(10):793-801. 2015.
Related Products / Services
Please note: All products are "FOR RESEARCH USE ONLY AND ARE NOT INTENDED FOR DIAGNOSTIC OR THERAPEUTIC USE"
